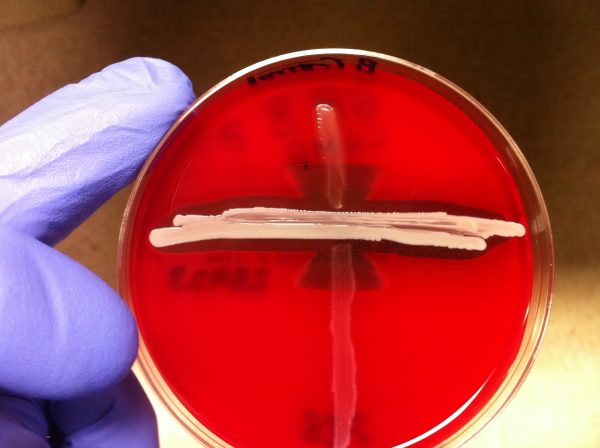
Κινδύνους από το strep-test εκτός ιατρείων δείχνουν οι εργαστηριακοί γιατροί

Τα τσιγάρα, τα ποτά και τα ξενύχτια: Τι έδειξε μελέτη 37 ετών για τους «βραδινούς τύπους»
Μελέτη που διήρκεσε 37 χρόνια έδειξε ότι δεν είναι το βιολογικό ρολόι που συνδέεται με πρόωρο θάνατο στους… ξενύχτηδες αλλά οι κακές συνήθειες που συνηθίζουν να έχουν σε σχέση με τους «πρωινούς» τύπους όπως το κάπνισμα και η κατανάλωση αλκοόλ.

Αριθμός Πιστοποίησης Μ.Η.Τ.232442
Αριθμός Πιστοποίησης Μ.Η.Τ.232442